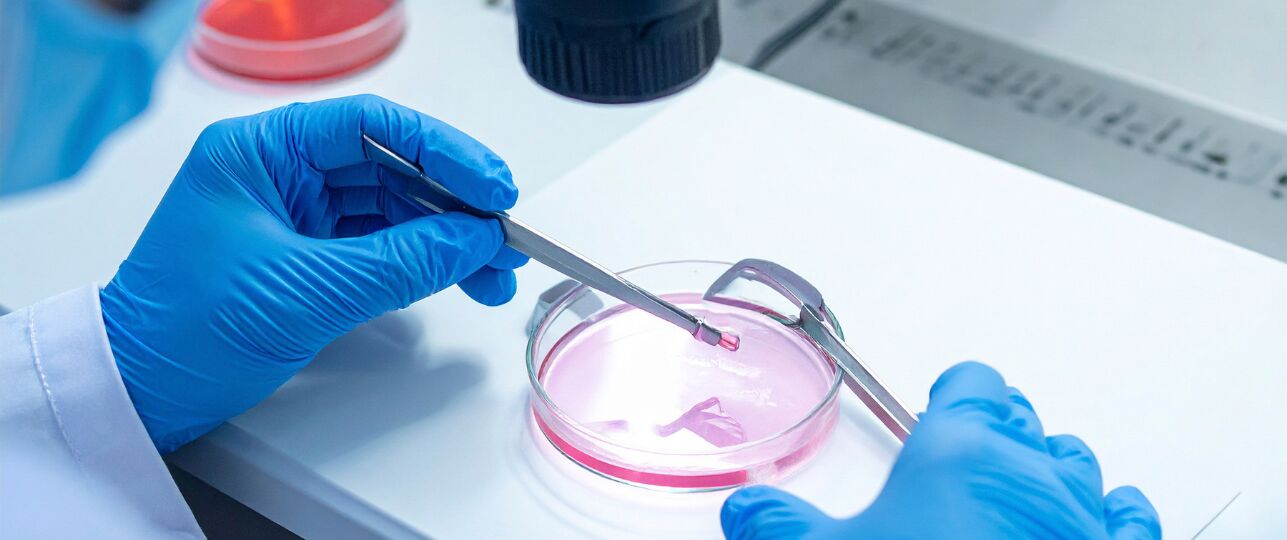
embryokweek

Bron: © Canva. Hoe denk jij over de embryokweek?
Bron: © Canva. Hoe denk jij over de embryokweek?
De Tweede Kamer heeft ingestemd met een ingrijpende wijziging van de Embryowet. Onder strikte voorwaarden mogen embryo’s voortaan speciaal worden gekweekt voor wetenschappelijk onderzoek. Een meerderheid van 90 Kamerleden stemde voor het wetsvoorstel, dat werd ingediend door D66’er Jan Paternotte en VVD’er Harry Bevers.
Daarmee zet Nederland een belangrijke, maar ook omstreden stap op het gebied van medisch-wetenschappelijk onderzoek.
Wat verandert er in de Embryowet?
Tot nu toe mochten onderzoekers alleen werken met embryo’s die waren overgebleven na een ivf-behandeling en al enkele dagen oud waren. De nieuwe wet maakt het mogelijk om embryo’s speciaal te creëren voor onderzoeksdoeleinden, zodat ook de allereerste ontwikkelingsfasen bestudeerd kunnen worden. Volgens de initiatiefnemers biedt dit kansen om ivf-behandelingen te verbeteren en erfelijke aandoeningen eerder op te sporen.
Wetenschappers geven al langer aan dat juist onderzoek naar zeer jonge embryo’s cruciale informatie kan opleveren. Zo kan beter worden onderzocht hoe embryo’s zich ontwikkelen en hoe de omstandigheden tijdens ivf-trajecten verder geoptimaliseerd kunnen worden.
Spanningen en verdeeldheid in de Kamer
De stemming over de wet was allesbehalve vanzelfsprekend. VVD, D66 en meerdere linkse partijen spraken hun steun uit, maar kwamen aanvankelijk net tekort voor een meerderheid. De doorslag kwam uiteindelijk van het CDA, waar de kwestie leidde tot stevige interne discussies.
CDA-leider Henri Bontenbal benadrukte voorafgaand aan de stemming dat het om een onderwerp gaat dat raakt aan persoonlijke overtuigingen en gewetensvragen. Daarom kregen CDA-Kamerleden de ruimte om zonder fractiediscipline te stemmen. Uiteindelijk stemde een meerderheid van de CDA-fractie vóór, waarmee het wetsvoorstel werd aangenomen. In totaal stemden 59 Kamerleden tegen.
Extra voorwaarden en strengere controle
Aan de wet zijn duidelijke en strenge voorwaarden verbonden. Elk onderzoeksvoorstel wordt afzonderlijk beoordeeld en mag niet omvangrijker zijn dan strikt noodzakelijk. Daarnaast heeft de Tweede Kamer extra waarborgen toegevoegd, mede op initiatief van het CDA.
Zo blijft de verplichting bestaan om voortdurend te zoeken naar alternatieve onderzoeksmethoden en worden de sancties aangescherpt voor onderzoekers die zich niet aan de regels houden. Hiermee wil de Kamer voorkomen dat de wet leidt tot onzorgvuldig of onethisch gebruik van embryo’s.
Bekijk hier de visie van Rob Jetten en lees daarna verder >>
Fundamentele bezwaren blijven bestaan
Vooral christelijke partijen zoals de ChristenUnie en de SGP blijven fel tegenstander van de wet. Zij vrezen een ‘glijdende schaal’ en vinden dat het bewust kweken van embryo’s voor onderzoek een morele grens overschrijdt. Volgens hen raakt deze wet aan fundamentele vragen over de waarde van menselijk leven en de rol van wetenschap daarin.
De indieners van het wetsvoorstel erkennen dat deze zorgen bestaan. Harry Bevers noemde het debat een zoektocht naar balans tussen ethiek, wetenschap, maatschappelijke belangen en levensbeschouwing.
Bekijk hier de argumenten van de Christenunie en lees daarna verder>>
Wat betekent dit besluit?
Voor wetenschappers en mensen met een onvervulde kinderwens kan de wetswijziging nieuwe perspectieven bieden. Tegelijkertijd blijft de maatschappelijke discussie over ethiek en grenzen van medisch onderzoek actueel. De wet gaat nu naar de Eerste Kamer, die zich nog over het voorstel moet buigen. Pas na goedkeuring daar wordt de Embryowet definitief aangepast.
Met dit besluit slaat Nederland een nieuwe weg in, waarbij medische vooruitgang en ethische afwegingen nauw met elkaar verweven blijven.
Bronnen:
Tweede Kamer, NOS Nieuws, Rijksoverheid